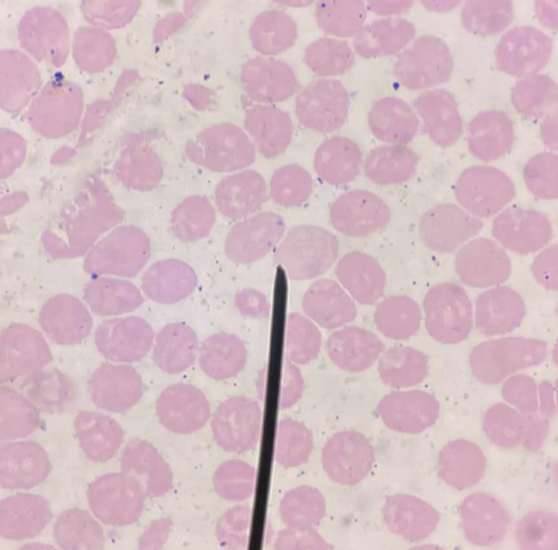
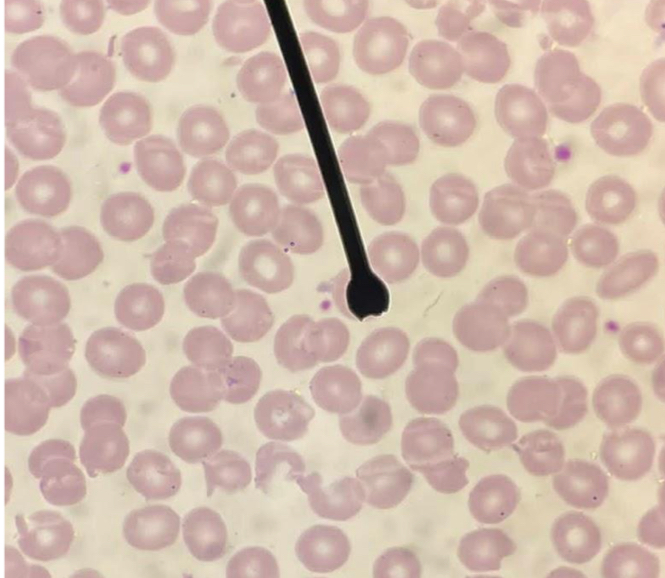

1/6
Looks like no tags are added yet.
Name | Mastery | Learn | Test | Matching | Spaced | Call with Kai |
|---|
No analytics yet
Send a link to your students to track their progress
A. Pronormoblast / Rubriblast / Erythroblast
B. Intensely / deeply basophilic cytoplasm
C. High
A. Identify the cell (Normoblastic / Rubriblastic / Erythroblastic)
B. Striking feature
C. Describe N:C ratio

A. Basophilic Normoblast / Prorubricyte / Basophilic Erythroblast
B. Parachromatin
C. Moderate
D. Deeply Basophilic
A. Identify the cell (Normoblastic / Rubriblastic / Erythroblastic)
B. Striking feature
C. Describe N:C ratio
D. Describe cytoplasm

A. Polychromatic normoblast / Rubricyte / Polychromatic erythroblast
B. Chunky chromatin
C. Low
D. Partial hemoglobinization
A. Identify the cell (Normoblastic / Rubriblastic / Erythroblastic)
B. Striking feature
C. Describe N:C ratio
D. What is responsible for its gray cytoplasm ?

A. Orthochromatic normoblast / Metarubricyte / Orthochromatic erythroblast
B. Pyknotic nucleus
C. Acidophilic / Acidophilia
A. Identify the cell (Normoblastic / Rubriblastic / Erythroblastic)
B. Striking feature
C. The pink coloration of the cytoplasm is due to what staining property?

A. Polychromatic erythrocyte
B. Pink, hollow cell
C. Dirty looking cytoplasm - Reticulo network
D. Remnants of karyorrhexis
E. Reticulocyte
A. Identify the cell (Normoblastic / Rubriblastic / Erythroblastic)
B. Striking feature if stained with Romanowsky stains
C. Striking feature if stained with supravital stains
D. The diffusely Basophilic staining of this cell is due to what ?
E. Term for this cell if stained with Supravital stain
A. Polychromasia / Polychromatophilia
B. Effective erythropoiesis
C. Low hematocrit and polychromatophilia is absent
D. Hypoxia
A. What’s the equivalent term of reticulocytosis in a wright stained smear?
B. What is the erythropoietic activity of the bone marrow ?
C. When do you say it’s ineffective?
D. What’s the danger of death for patients with ineffective erythropoiesis?

A. Normocyte / Erythrocyte / Discocyte
B. Central area of pallor
C. Biconcave disc shape
D. Discoid shape
A. Identify the cell (Normoblastic / Rubriblastic )
B. Striking feature if stained with Romanowsky stains
C. Characters structure responsible for its deformability and flexibility
D. Actual shape